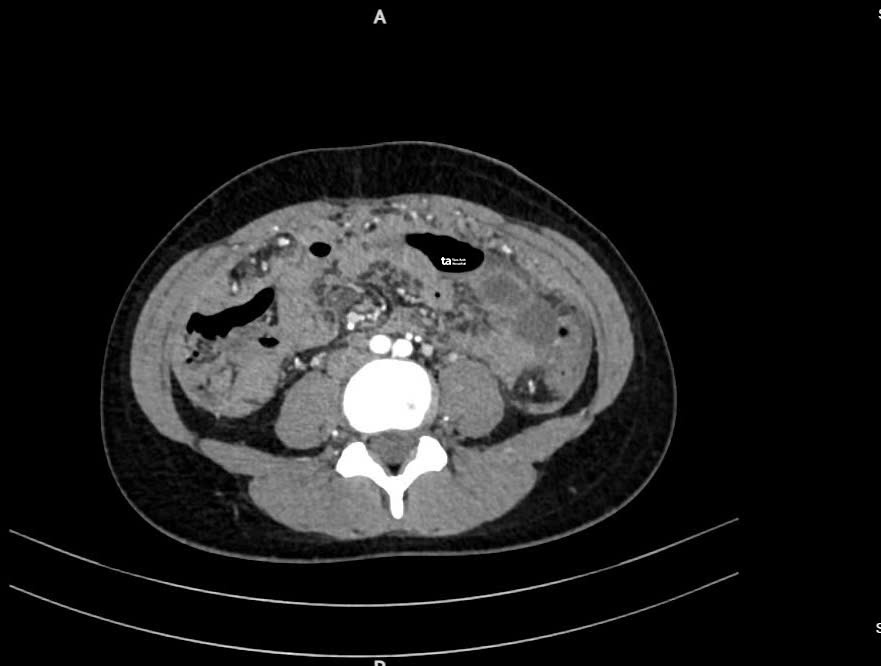

Lao màng bụng gây ứ dịch tiêu hóa
2024-09-16 HaiPress
Chị Hà được bác sĩ một bệnh viện chẩn đoán viêm ruột,nghi ngờ lao ruột,chỉ định theo dõi. Sau đó chị đau bụng nhiều hơn kèm buồn nôn,sốt,cơ thể lạnh run,siêu âm và chụp CT tại Bệnh viện Đa khoa Tâm Anh TP HCM cho thấy nhiều dịch trong ổ bụng. Các bác sĩ hút ra khoảng hai lít dịch màu vàng nhạt trong bụng của chị Hà. ThS.BS.CKI Lưu Xuân Phát,Trung tâm Nội soi và Phẫu thuật Nội soi Tiêu hóa,cho biết đây là nguyên nhân khiến người bệnh tăng cân dù chán ăn. Sau khi hút hết dịch,các triệu chứng trên bắt đầu giảm.
Xét nghiệm PCR (Polymerase Chain Reaction) dịch để tìm vi khuẩn lao,kết quả âm tính,tuy nhiên chỉ số CA125 (chất chỉ điểm ung thư hiện diện với nồng độ cao trong máu khi có các tế bào u) tăng gấp 10 lần so với người bình thường. "Chỉ số này tăng có thể do lao cũng có thể do ung thư",bác sĩ Phát nói,thêm rằng phác đồ điều trị hai tình trạng này khác nhau nên cần sinh thiết màng bụng để chẩn đoán chính xác nguyên nhân.
Mổ nội soi lấy mô màng bụng làm giải phẫu bệnh,BS.CKI Hoàng Mạnh Chinh,phát hiện bệnh nhân bị tổn thương viêm hạt hoại tử do lao (lao màng bụng).
Ảnh cắt lớp vi tính (CT) cho thấy dịch chứa đầy ổ bụng (khoảng màu trắng). Ảnh: Bệnh viện Đa khoa Tâm Anh
Lao màng bụng là tình trạng tổn thương viêm của màng bụng do vi khuẩn lao gây nên,thường xuất hiện thứ phát sau lao phổi. Tùy theo độc tố,số lượng vi khuẩn lao và tình trạng hệ miễn dịch,mức độ triệu chứng khác nhau,thường gặp là sốt về chiều,đau bụng,bụng chướng do có dịch. Ở giai đoạn muộn,bệnh có thể gây tắc ruột.
"Những triệu chứng này dễ nhầm lẫn với các bệnh tiêu hóa khác như viêm ruột thừa,tắc ruột,viêm phúc mạc do nguyên nhân ngoài lao,ung thư màng bụng nguyên phát hoặc thứ phát sau ung thư đại tràng,buồng trứng...",bác sĩ Phát cho biết,ngày 16/9,khuyến cáo người xuất hiện triệu chứng bất thường ở bụng và nghi ngờ tràn dịch ổ bụng,cần đến bệnh viện khám.

Các bác sĩ thực hiện một ca phẫu thuật nội soi. Ảnh: Bệnh viện Đa khoa Tâm Anh
Nếu có tràn dịch ổ bụng,người bệnh cần được xét nghiệm chuyên sâu để xác định nguyên nhân. Trường hợp do lao,người bệnh được điều trị bằng thuốc hoặc can thiệp ngoại khoa nếu có biến chứng.
Quyên Phan
*Tên bệnh nhân đã được thay đổi
Độc giả đặt câu hỏi về bệnh tiêu hóa tại đây để bác sĩ giải đáp
